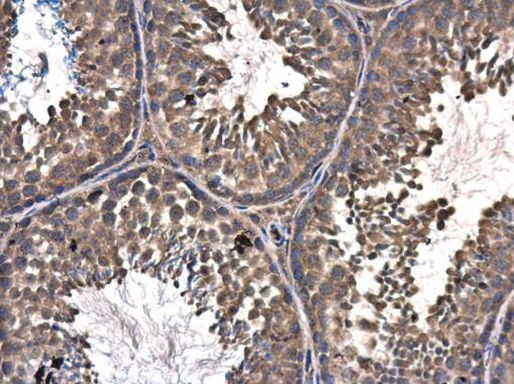
ASZ1 Antibody in Immunohistochemistry (Paraffin) (IHC (P))

Search
Invitrogen
ASZ1 Polyclonal Antibody
{{$productOrderCtrl.translations['antibody.pdp.commerceCard.promotion.promotions']}}
{{$productOrderCtrl.translations['antibody.pdp.commerceCard.promotion.viewpromo']}}
{{$productOrderCtrl.translations['antibody.pdp.commerceCard.promotion.promocode']}}: {{promo.promoCode}} {{promo.promoTitle}} {{promo.promoDescription}}. {{$productOrderCtrl.translations['antibody.pdp.commerceCard.promotion.learnmore']}}

Please note: We are reviewing Western blot images included in the antibody testing data in our catalog, including those provided by third parties. Unless expressly labeled or annotated as “raw-unedited”, Western blot images included in the antibody testing data in our catalog may have been edited, optimized or otherwise adjusted for presentation.
产品信息
PA5-35858
种属反应
宿主/亚型
分类
类型
抗原
偶联物
形式
浓度
规格
纯化类型
保存液
内含物
保存条件
RRID
产品详细信息
Store product as a concentrated solution. Centrifuge briefly prior to opening the vial.
Predicted reactivity: Mouse (83%), Rat (84%), Cat (89%), Rabbit (89%), Sheep (86%), Rhesus Monkey (97%), Chimpanzee (99%), Bovine (87%).
靶标信息
Plays a central role during spermatogenesis by repressing transposable elements and preventing their mobilization, which is essential for the germline integrity. Acts via the piRNA metabolic process, which mediates the repression of transposable elements during meiosis by forming complexes composed of piRNAs and Piwi proteins and governs the methylation and subsequent repression of transposons. Its association with pi-bodies suggests a participation in the primary piRNAs metabolic process. Required prior to the pachytene stage to facilitate the production of multiple types of piRNAs, including those associated with repeats involved in the regulation of retrotransposons. May act by mediating protein-protein interactions during germ cell maturation.
⚠WARNING: This product can expose you to chemicals including mercury, which is known to the State of California to cause birth defects or other reproductive harm. For more information go to www.P65Warnings.ca.gov.
仅用于科研。不用于诊断过程。未经明确授权不得转售。
篇参考文献 (0)
生物信息学
蛋白别名: Ankyrin repeat, SAM and basic leucine zipper domain-containing protein 1; Ankyrin-like protein 1; asz1; germ cell-specific ankyrin, SAM and basic leucine zipper domain containing protein; Germ cell-specific ankyrin, SAM and basic leucine zipper domain-containing protein
基因别名: 4933400N19Rik; ALP1; ANKL1; ASZ1; C7orf7; GASZ; ORF3
UniProt ID: (Mouse) Q8VD46
Entrez Gene ID: (Mouse) 74068